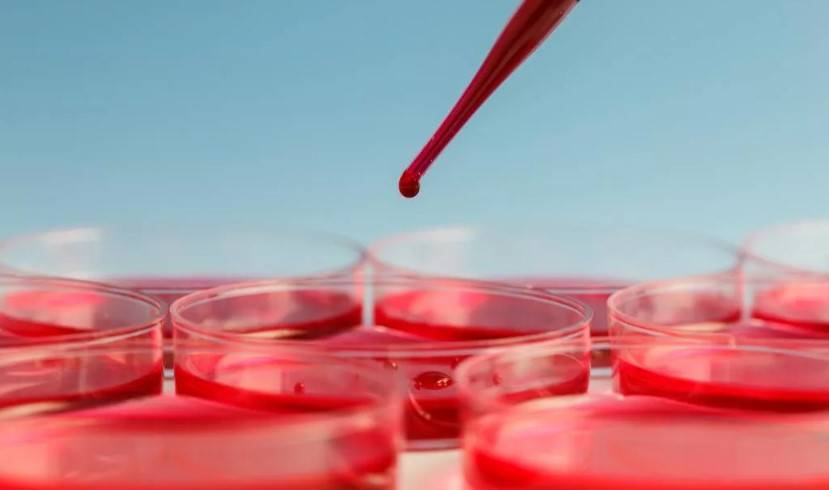

Лечение анемии
Чтобы справиться с малокровием, необходимо устранить его причину – вылечить заболевания пищеварительной системы, остановить кровотечение, откорректировать аутоиммунные патологии, устранить воздействие негативных факторов и др.
При выборе способа лечения врач учитывает тип и стадию болезни, симптоматику, возраст пациента.
При железодефицитной анемии назначают железосодержащие препараты. Дополнительно врач рекомендует ввести в рацион продукты, насыщенные легкоусвояемым железом.
Лечение мегалобластной анемии заключается во внутримышечном введении витамина В12. Дополнительно врач может назначить фолиевую кислоту.
При постгеморрагической анемии первостепенная цель – устранение источника кровопотери. Затем приступают к переливанию коллоидных растворов (протеина, альбумина).
При гемолитической форме лечение заключается в применении иммунодепрессантов, цитостатиков, гормональных препаратов. При необходимости проводят плазмаферез, переливание плазмы или крови, пересадку костного мозга. В тяжелых случаях, при развитии гемолитического криза, может возникнуть необходимость в удалении селезенки. Чтобы предотвратить инфекционные осложнения, назначают антибиотики.
Апластическую анемию лечат анаболическими гормонами, глюкокортикостероидами, иммунодепрессантами. Дополнительно назначают витаминные комплексы. Может понадобиться антибактериальная терапия, использование факторов роста кровяных клеток, переливание тромбоцитарной или эритроцитарной массы. Если консервативная терапия оказывается неэффективной, врач рекомендует операцию, во время которой удаляет селезенку или выполняет трансплантацию костного мозга.
При сидероахрестическом малокровии необходимы десферал, пиридоксальфосфат, витамин В6.
При легкой форме анемии лечение продолжается 3 месяца (симптомы исчезают через неделю), при средней – 4,5 месяцев, а при тяжелой – полгода.

Железодефицитная анемия

Низкий гемоглобин вредит IQ
Американские ученые провели исследование, которое показало взаимосвязь низкого уровня гемоглобина и упадка умственных способностей. Подростков, у которых диагностировали железодефицит, попросили выполнить тестовое задание. После лечения эти же ребята показывали гораздо более высокие показатели в учебе.
Как выявить железодефицитную анемию?
Определить низкий уровень гемоглобина поможет обычный анализ крови. А вот заподозрить признаки железодефицита ты можешь и сам(-а). Кстати, чаще всего проблема беспокоит девушек. Особенно если уже начались менструации — дополнительный источник кровопотери.
Признаки железодефицита:
- Бледность и сухость кожи;
- ломкие ногти;
- сухие волосы, которые истончаются на концах и секутся. Девушки тратят множество денег на дорогие шампуни и кремы. Но в случае наличия дефицита железа одна косметика не поможет;
- появление ранних мимических морщин;
- головокружение, слабость;
- апатия, ощущение отсутствия сил, усталости;
- невозможность сконцентрироваться и запомнить информацию;
- нетипичные вкусовые пристрастия. Шутки про то, как кто-то любит погрызть мел, вполне могут иметь под собой медицинскую причину: у человека низкий гемоглобин!
Сколько лечиться?
Лечение при обнаружении железодефицитной анемии несложное, но требует дисциплины. По определенной схеме, которую индивидуально подбирает врач, нужно принимать препараты железа. Это могут быть таблетки или сироп. Делать это необходимо долго: около трех месяцев
Ведь важно не только поднять показатели гемоглобина, но и насытить железом ткани. А это значит, улучшить состояние кожи, ногтей, волос, слизистых
Людмила Смирнова, зав. кафедрой клинической гематологии и трансфузиологии БелМАПО, доктор медицинских наук: «Как только мы ликвидируем анемию, тканевой дефицит железа, у молодого человека нет одышки, слабости, у него появляется желание активности: бегать, ездить на велосипеде и т. д. Это имеет большое значение. Ведь дефицит железа накладывает отпечаток на психику. Он дает некоторую серость восприятия. Юноши и девушки становятся более внушаемыми, потому что из-за постоянной гипоксии мозга (недостаток кислорода) немного по-другому смотрят на мир».

Питание — в помощь
В народе ходит мнение, что гемоглобин можно поднять при помощи определенного питания. Доля правды в этом есть: еда поможет поддерживать уровень гемоглобина. Однако при наличии железодефицита без специального лечения уже не обойтись.
Что нужно есть при железодефицитной анемии и для ее профилактики? В первую очередь, это:
- Красное мясо (говядина, телятина);
- Красная рыба (благородных сортов — сёмга, форель и др.);
- Гречневая каша.
Людмила Смирнова: «Наш организм способен всасывать лишь 2 мг железа в сутки. Причем лучше всего мы «берем» его из красного мяса и рыбы. Мясо курицы, цыпленка содержит много белка, но мало железа. Из растительных продуктов мы способны усвоить только 3−4% железа. Лидер здесь — гречка. Но и из нее мы всасываем лишь 7% железа. Другие крупы (овсяная, пшенная, рисовая) железа вообще не содержат. Многие любят питаться так: съесть кусок сала, драники. По калорийности эта пища очень высока. Однако в ней отсутствует железо».
Не очень обнадеживающая новость: сам по себе дефицит железа не пройдет. А это значит, что со временем все его признаки начнут усиливаться: ты можешь еще больше уставать, чувствовать упадок сил, головную боль, «абыякавасць да жыцця». Хорошая новость: всего лишь только прием препаратов железа может помочь тебе лучше выглядеть и ощущать желание жить активно. А еще использовать свой ум по-максимуму. Поделись открытием со своими друзьями. И обязательно — с лечащим врачом!
Анемия у взрослых и детей
Чаще всего малокровие развивается в детском возрасте. От нее страдает 47,4% дошкольников и 25,4% школьников. Но нередко подобный диагноз ставят и взрослым.
Основная причина понижения гемоглобина у детей – быстрый рост, требующий много питательных веществ, и недостаточно отлаженный механизм кроветворения.
Еще одна частая причина детского малокровия – паразитарные заболевания. У новорожденных малышей обычно малокровие наблюдается, если материнский организм при беременности испытывал дефицит железа.
В легкой степени анемия не представляет опасности для детского организма, но она ослабляет иммунную систему, что способствует развитию различных заболеваний, затормаживает набор веса.
У взрослых людей при отсутствии своевременного лечения анемия способна спровоцировать гипоксическую кому. В некоторых случаях (при сильной кровопотере) возможен летальный исход. Поэтому не стоит игнорировать проблему. При появлении первых признаков болезни следует обратиться к врачу.
Виды анемии
В зависимости от причины различают 4 группы патологии:
- Дефицитная анемия – возникает при недостатке веществ, участвующих в процессе кроветворения.
- Постгеморрагическая анемия – вызвана острой или хронической потерей крови.
- Гемолитическая анемия – результат сокращения длительности жизни эритроцитов из-за усиленного разрушения.
- Гипопластическая, или апластическая, анемия (самая тяжелая форма) – развивается при нарушении кроветворной функции из-за ослабления способности костного мозга синтезировать кровяные клетки (эритроциты).
Известно несколько разновидностей дефицитной патологии:
- Железодефицитная анемия (встречается наиболее часто). Возникает при недостатке в организме железа, входящего в состав гемоглобина.
- В12-дефицитная анемия. Проявляется при дефиците витамина В12, необходимого для созревания эритроцитов и правильного функционирования нервной системы.
- Фолиеводефицитная анемия. Развивается при недостатке витамина В9 (фолиевой кислоты) в результате его недостаточного поступления в организм либо избыточного выведения.
Самые распространенные формы гемолитической анемии:
- Талассемия. Понижается скорость синтеза гемоглобина. К тому же он неполностью формируется, становится нестабильным, придает эритроцитам мишеневидную форму.
- Серповидно-клеточная анемия. В организме синтезируется дефектный гемоглобин, из-за чего эритроциты приобретают серповидный вид. Они разрушают друг друга острыми концами, повышают вязкость крови, закупоривают капилляры.
Вид анемии определяется врачом — терапевтом или гематологом на основе анализов крови.
Симптомы анемии
Признаки патологии зависят от ее вида и степени тяжести. Легкая форма часто протекает бессимптомно. Возможны общая слабость, повышенная утомляемость, ослабление внимания. В тяжелых случаях (при понижении гемоглобина ниже 50 г/л) может развиться ацидоз (закисление крови), сердечная недостаточность.
К общим признакам, сопровождающим все виды анемии, принадлежат:
- головная боль, головокружение;
- летание «мушек» перед глазами;
- шум или звон в ушах;
- усиленное сердцебиение, одышка;
- сухость, шелушение и бледность кожи;
- понижение мышечного тонуса;
- резкая смена настроения, раздражительность;
- общая слабость, сонливость;
- понижение работоспособности, быстрая утомляемость.
Для железодефицитной формы характерны наличие трещин и заед в углах рта, поперечная исчерченность, слоистость и ломкость ногтей, сечение и выпадение волос, искажение вкусовых предпочтений (желание есть мел, землю), понижение артериального давления, обмороки.
При В12-дефицитной анемии человек ощущает покалывание и онемение в пальцах, чувство ползания мурашек, скованность и отечность конечностей, кожа приобретает желтоватый оттенок, а язык – малиновый, походка становится шаткой.
При апластическом малокровии в грудной области возникают колющие боли, физические усилия сопровождаются одышкой. На коже появляются мелкие кровоизлияния (петехии) в виде красной сыпи, кровоточат десны, менструации становятся длительными и обильными.
При фолиеводефицитной форме затрудняется пережевывание и глотание пищи, атрофируются слизистые оболочки ЖКТ, развивается непереносимость кислой пищи.
При постгеморрагической анемии кружится голова, понижаются давление и температура тела, учащается (но становится слабым) пульс, появляется холодный пот. Если кровотечение обильное, то возможны судороги, коматозное состояние и даже остановка сердца.
Для гемолитического малокровия характерны желтушность кожи и слизистых оболочек, потемнение мочи и кала, повышенная температура тела, увеличение размеров печени или селезенки.
При гипопластической форме усиливается кровоточивость десен, в ротовой полости образуются язвы, на коже появляются синяки, развивается тахикардия, постоянно хочется спать.
Классификация болезни
Выделяют 5 основных видов анемии:
Постгеморрагическая
Развивается вследствие сильных кровопотерь, вызванных травмами, хирургическими вмешательствами, внематочной беременностью, язвенной болезнью, заболеваниями крови, легких, печени. Приводит к сосудистой недостаточности и кислородному голоданию.
Для взрослого человека серьезная угроза для здоровья возникает при потере 500 миллилитров крови.
Дефицитная
Вызвана дефицитом витаминов или минеральных элементов, необходимых для кроветворения.
Известно 3 самых распространенных разновидности дефицитных анемий:
Железодефицитная
Самый распространенный тип. Диагностируется в 80% случаев. Возникает при малом количестве элементов железа в организме.
В12-дефицитная (мегалобластная, пернициозная, болезнь Аддисона-Бирмера)
Развивается когда в организма недостаточное количество витамина В12 (цианокобаламина). Подобная ситуация наблюдается при сбоях синтеза гликопротеина, контролирующего количество витамина В12.
Часто болезнь диагностируется у пожилых людей, пациентов с атрофией слизистой желудка, энтеритом, редко у беременных женщин.
Фолиеводефицитная
Характеризуется дефицитом витамина В9 (фолиевой кислоты)
Гемолитическая
Недостаток эритроцитов наблюдается из-за их интенсивного разрушения. При этом может повышаться концентрация свободного гемоглобина, гемосидерина, билирубина. Чтобы компенсировать потери, организм начинает активно вырабатывать новые эритроциты, но они будут незрелыми и не могут в полной мере выполнять возложенную на них функцию.
Гемолитическое малокровие бывает врожденным (обуславливается дефектами генов) и приобретенным. Оно может развиться при несовместимости крови беременной женщины и ребенка, интоксикации организма, переливании неподходящей крови, приеме ряда лекарственных средств, наличии злокачественных новообразований.
Самые распространенные наследственные разновидности:
Серповидноклеточная анемия
Характерная особенность – наличие в крови дефектных эритроцитов, по форме напоминающих полумесяц. Они не только не могут выполнять свою работу, но и способны закупоривать сосуды.
Талассемия
Для нее характерная мишеневидная форма эритроцитов.
Минковского-Шоффара
Для нее характерен сфероцитоз эритроцитов
Апластическая
Результат подавления кроветворной способности костного мозга в результате употребления лекарств, иммунных патологий, влияния химических веществ, ионизирующего облучения и др. Помимо понижения уровня эритроцитов, наблюдается уменьшение числа тромбоцитов, лейкоцитов и клеток костного мозга. Поэтому апластическая анемия часто сопровождается тромбоцитопенией, анемией, лейкопенией.
Апластическая анемия бывает наследственной и приобретенной.
Сидероахрестическая
Заболевание наследственного характера, в основном встречается у мужчин. В эритроцитах снижается содержание гемоглобина, а в организме накапливается свободное железо
Также различают анемии:
— микроцитарные – эритроциты мелкие, содержат мало гемоглобина;
— нормоцитарные – эритроциты имеют нормальный размер, но их количество уменьшенное;
— макроцитарные – эритроциты большие, но гемоглобина в них мало.
Лечение повышенного гемоглобина у ребенка
Если гемоглобин выше нормы у ребенка, то необходимо соответствующее лечение. В первую очередь необходимо давать ему чаще питье. Во-вторых, придется исключить из рациона продукты, которые увеличивают уровень гемоглобина в крови. К ним относится еда с высоким содержанием железа: говядина, печень, яблоки, гранат, гречневая каша. Лучше всего давать ребенку больше куриного мяса (особенно белого), морепродуктов, нежирной рыбы.
Необходимо проследить, чтобы у ребенка были минимальные физические нагрузки. Также важен нормальный уровень влажности в помещении. В более тяжелых случаях доктор подберет специальные медикаменты, которые будут разжижать кровь. Если рост показателя связан с какой-либо патологией, то требуется лечение основного недуга.
Причины возникновения анемии
Известно 3 основные причины развития анемии: замедление синтеза эритроцитов, преждевременное их разрушение, потеря с кровью.
Спровоцировать подобное состояние способны разнообразные факторы:
— наследственная предрасположенность;
— хронические кровотечения (носовые, желудочно-кишечные, маточные, геморроидальные);
— кровотечения, вызванные ранами и травмами;
— обильные и продолжительные менструации;
— ослабление кроветворной функции;
— усиленное разрушение эритроцитов;
— аутоиммунные заболевания (синдром Шегрена, системная красная волчанка);
— неправильное питание – недостаток в рационе продуктов, содержащих железо и витаминов группы В;
— соблюдение строгих диет, отказ от белковой пищи;
— болезни желудочно-кишечного тракта, нарушающие процесс всасывания железа либо витаминов (энтерит, рак, болезнь Крона);
— заболевания, снижающие содержание гемоглобина (нефротический синдром, патологии печени, алиментарная недостаточность);
— ухудшение выработки эритропоэтина – гормона, активирующего синтез эритроцитов;
— патологии селезенки;
— инфекционные заболевания;
— воздействие химических веществ (бензола, мышьяка, солей тяжелых металлов, ароматических углеводородов);
— прием лекарственных препаратов (НПВС, сульфаниламидов, левомицетина, анальгина, цитостатиков);
— онкологические заболевания;
— хирургические вмешательства;
— прохождение химиотерапии;
— воздействие токсических веществ.

овышается риск развития анемии у:
* Профессиональных спортсменов. При усиленных физических нагрузках мышцы нуждаются в повышенном количестве железа. В случае недостаточного восполнения этого элемента снижается гемоглобин.
* Вегетарианцев. Из-за отсутствия в рационе мяса они не получают необходимого количества железа, витаминов и микроэлементов..
* Доноров.
* Беременных и кормящих женщин.
* Пожилых людей.
Диагностика анемии
а первичном приеме врач проведет общий осмотр пациента, выслушивает жалобы, изучит анамнез (историю) болезни – расспросит о наличии профессиональных вредностей, особенностях питания, сопутствующих и наследственных заболеваниях, приеме лекарств.
Чтобы установить точный диагноз, необходимо сделать анализы крови для определения:
— количества форменных элементов крови (эритроцитов, лейкоцитов, тромбоцитов);
— числа ретикулоцитов;
— эритроцитарных индексов;
— лейкоцитарной формулы;
— гематокрита;
— среднего объема эритроцитов;
— скорости оседания эритроцитов (СОЭ);
— ферритина, известного как маркер воспалений.
На основании результатов лабораторных исследований врач определит тип анемии, выяснит причину болезни, оценит общее состояние организма и подберет оптимальные методы лечения.
Чтобы уточнить полученную информацию, врач может направить на инструментальную диагностику:
— рентгенографию легких;
— фиброгастродуоденоскопию;
— УЗИ почек, печени, органов малого таза;
— компьютерную томографию.
Для выявления гемолитической анемии могут понадобиться генетические анализы.
Симптомы анемии
Клиническая картина может видоизменяться в зависимости от вида патологии.
Железодефицитная форма часто сопровождается:
* сухостью и шелушением кожи;
* сечением, ломкостью и выпадением волос;
* искривлением, истончением и ломкостью ногтей, поперечной исчерченностью;
* затруднениями при глотании сухой пищи;
* жжением языка;
* извращением вкуса – пристрастием к поеданию теста, сырого мяса, мела, глины, земли, зубной пасты;
* извращением обоняния – желанием нюхать вещества с резки запахом (краску, бензин, лак, ацетон);
* появлением заед (трещин в уголках рта);
* запорами;
* нарушением менструального цикла.
Для В12-дефицитной анемии характерны внезапная слабость, нарушение пищеварения, желто-лимонный цвет кожи, парестезии (онемение, ощущение покалывания, ползания мурашек), нейропатии, стоматит, депрессия, раздражительность, психоз. При тяжелом протекании болезни возможны галлюцинации, бред, психические нарушения, развитие атрофического гастрита, деменции.
При фолиеводефицитном малокровии симптомы аналогичны, но отсутствует неврологическая симптоматика. Могут учащаться эпилептические приступы, обостряться проявления шизофрении.
При постгеморрагической анемии в результате сильной кровопотери возможны сухость в ротовой полости, жажда, головная боль, головокружение, учащение сердцебиения, обморочное состояние, понижение температуры тела.
При гемолитическом малокровии увеличивается селезенка, появляется боль в правом подреберье, развивается желтуха, появляется склонность к формированию камней в желчных путях. Возможны дефекты лицевого скелета, потемнение мочи. Если развивается гемолитический криз, то часто наблюдаются тошнота, рвота, судороги, расстройство сознания, сердечно-сосудистая или почечная недостаточность.
При апластической форме часто развиваются инфекционные осложнения.
Сидероахрестическая анемия на начальных стадиях ничем не проявляет себя. Со временем развивается анемический синдром, увеличиваются размеры печени и селезенки, происходят сбои в функционировании половых желез. Возможно возникновение сахарного диабета, сердечной недостаточности.
Причины повешенного гемоглобина у ребенка
Причины повышения гемоглобина у ребенка чаще всего связаны с избыточным содержанием эритроцитов в крови и нехваткой количества плазмы. Очень часто такое явление указывает на то, что организм потерял много жидкости, из-за чего кровь сгущается. Именно такая причина у детей считается наиболее распространенной. Она спровоцирована интенсивным выделением пота, перенапряжением нервной системы, теплым и сухим воздухом, употреблением чая с мочегонным действием, а также лихорадкой.
К патологическим причинам относится следующее:
- заболевания крови;
- кишечную непроходимость;
- почечные болезни, из-за которых в большом количестве синтезируется эритропоэтин;
- врожденные сердечные заболевания, фиброз легких и легочное сердце (в этих случаях повышенный уровень содержания эритроцитов компенсирует дефицит кислорода);
- тяжелые формы ожогов (в этом случае усиливается синтез эритроцитов, чтобы помогать доставлять питательные компоненты и кислород к пораженным областям тела, а это способствует более быстрому заживлению);
- синдром Вакеза-Ослера. Еще это заболевание называют эритремией либо полицитемией. При этом недуге в костном мозге вырабатывается избыточное количество эритроцитов.
Также могут быть повышены эритроциты и гемоглобин у ребенка, если он курит. В подростковом возрасте влияют частые стрессы, а также прием анаболических стероидных препаратов, если ребенок занимается спортом.
Особенности питания
Важное значение приобретает коррекция питания. В меню должны входить:
В меню должны входить:
— зелень, зеленые овощи (содержат в повышенных концентрациях фолиевую кислоту);
— мясо, сливки, масло (богаты белками и аминокислотами);
— печень, рыба, грибы, яйца, морепродукты, говядина, бобовые, гречка, шпинат, изюм, чернослив, яблоки, инжир, сливовый сок (насыщены железом);
— гранатовый сок (повышает уровень гемоглобина);
— морковь, кукуруза, бобовые, овсяная каша, абрикосы, помидоры (улучшают кроветворение).
Рекомендуется ограничить потребление жирной пищи, сдобных изделий, кофе, чая, алкоголя.
Симптомы повешенного гемоглобина у ребенка
Симптомы повышенного гемоглобина будут сохраняться в течение долгого времени. Как правило, у ребенка появляются такие признаки:
- сильная сонливость, слабость, быстрая утомляемость;
- плохой аппетит;
- головокружение и головные боли, обмороки;
- проблемы со зрением и слухом;
- появление синяков даже при небольшой пальпации;
- аритмия, тахикардия;
- посинение или побледнение кончиков пальцев и губ, онемение.
Кроме этих симптомов повышенного гемоглобина еще могут быть обнаружены кровяные сгустки в каловых массах. У некоторых после купания в воде ощущается зуд. Также могут возникать проблемы с органами мочевыводящей системы, а также начинается резкое похудение.
Противопоказания при анемии
Единственное противопоказание при лечении малокровия – индивидуальная непереносимость определенных медикаментов. В таком случае врач подберет альтернативные лекарства, которые позволят получить положительный результат.
Беременным женщинам и младенцам подбирают безопасные препараты, не вызывающие побочных явлений.
При своевременном обращении к врачу, благодаря медикаментозному лечению, коррекции рациона и изменению образа жизни, удается без труда устранить проблему и восстановить правильное функционирование организма. Поэтому не теряйте время, не занимайтесь самолечением, при ухудшении самочувствия, обращайтесь к врачу.

Ресурсы




































